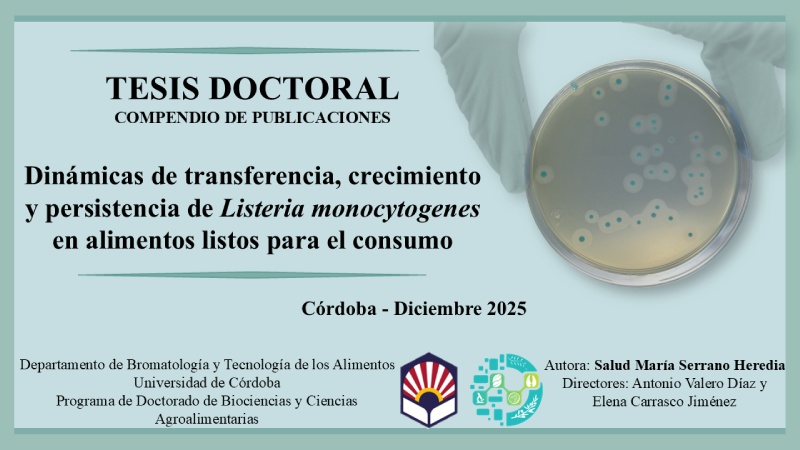

Tesis doctorales | 2025
Doctorando: Salud Serrano Heredia
Directores: Antonio Valero Díaz, Elena Carrasco Jiménez
Universidad: Universidad de Córdoba
Fecha: diciembre 2025

Doctorando: María Auxiliadora Badillo Viloria
Directores: Ignacio García Bocanegra, David Cano Terriza
Universidad: Universidad de Córdoba
Fecha: diciembre 2025

Doctorando: Carmen Entrenas García
Directores: Juan J. Garrido, Sara Zaldívar López
Universidad: Universidad de Córdoba
Fecha: noviembre 2025

Doctorando: Laura Rabasco Vílchez
Directores: Fernando Pérez Rodríguez, Araceli Bolívar Carrillo
Universidad: Universidad de Córdoba
Fecha: octubre 2025

Doctorando: Anabel Expósito Díaz
Directores: Juan Moral Moral, Feliciano Priego Capote
Universidad: Universidad de Córdoba
Fecha: julio 2025

Doctorando: Irene Agulló Ros
Directores: MªÁngeles Risalde Moya, Mercedes Domínguez Rodríguez, Jose Carlos Gómez Villamandos
Universidad: Universidad de Córdoba
Fecha: marzo 2025
